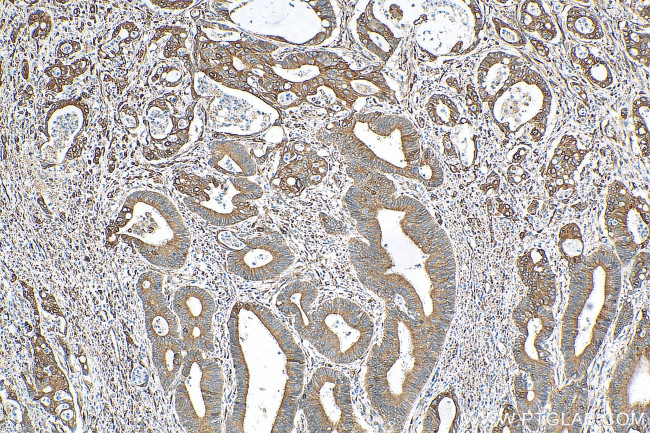
PRC1 Antibody in Immunohistochemistry (Paraffin) (IHC (P))

Search
Proteintech
PRC1 Polyclonal Antibody
{{$productOrderCtrl.translations['antibody.pdp.commerceCard.promotion.promotions']}}
{{$productOrderCtrl.translations['antibody.pdp.commerceCard.promotion.viewpromo']}}
{{$productOrderCtrl.translations['antibody.pdp.commerceCard.promotion.promocode']}}: {{promo.promoCode}} {{promo.promoTitle}} {{promo.promoDescription}}. {{$productOrderCtrl.translations['antibody.pdp.commerceCard.promotion.learnmore']}}
产品信息
10110-2-AP
种属反应
宿主/亚型
分类
类型
抗原
偶联物
形式
浓度
规格
纯化类型
保存液
内含物
保存条件
运输条件
产品详细信息
Immunogen sequence: VCLQKALNH LREIWELIGI PEDQRLQRTE VVKKHIKELL DMMIAEEESL KERLIKSISV CQKELNTLCS ELHVEPFQEE GETTILQLEK DLRTQVELMR KQKKERKQEL KLLQEQDQEL CEILCMPHYD IDSASVPSLE ELNQFRQHVT TLRETKASRR EEFV (13-175 aa encoded by BC005140)
靶标信息
This gene encodes a protein that is involved in cytokinesis. The protein is present at high levels during the S and G2/M phases of mitosis but its levels drop dramatically when the cell exits mitosis and enters the G1 phase. It is located in the nucleus during interphase, becomes associated with mitotic spindles in a highly dynamic manner during mitosis, and localizes to the cell mid-body during cytokinesis. This protein has been shown to be a substrate of several cyclin-dependent kinases (CDKs). It is necessary for polarizing parallel microtubules and concentrating the factors responsible for contractile ring assembly.
仅用于科研。不用于诊断过程。未经明确授权不得转售。
篇参考文献 (0)
生物信息学
蛋白别名: anaphase spindle elongation 1 homolog; MGC1671; MGC3669; prc1; protein regulating cytokinesis 1; Protein regulator of cytokinesis 1; unnamed protein product
基因别名: ASE1; D7Ertd348e; MAP65; PRC1
UniProt ID: (Human) O43663, (Mouse) Q99K43
Entrez Gene ID: (Human) 9055, (Mouse) 233406, (Rat) 308761